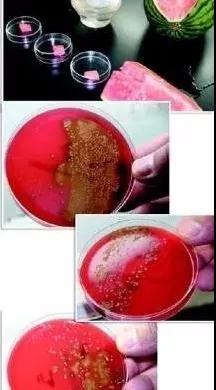

西瓜这么吃不是解暑,而是比砒霜还毒!安全吃瓜,要学会这6点!
- 2019-08-08 09:30:00
- 翼猫科技 原创
- 0
炎炎夏日,西瓜是最佳消暑果品, 清热解暑、除烦止渴、还利小便
不吃西瓜的夏天,就像没有了灵魂!
而每个人吃西瓜的方法也不太一样。 常规版:切成小块,一块块慢慢吃;
井字法
进阶版:对半切,拿勺子挖着吃。
这样吃比较爽。
文艺版:花式切,砌成果盘,叉着吃。
竹签法
但近日,一块在冰箱里放了两天的西瓜,险些让西安一名8岁的男孩丢了命,幸亏医护人员全力救治,才避免悲剧的发生。
据了解,小男孩喜欢吃西瓜,不久前他发现冰箱里有一块已放了2天的西瓜,就非要吃。谁知道晚上就出现了发热、上吐下泻。连夜到医院,医生判断为急性胃肠炎合并脱水,给了抗感染及补液治疗,液体输完后孩子精神状态明显好转。
第2天情况再次反复,体温高达39℃,专家会诊考虑患儿重症感染性腹泻病合并中度脱水、中毒性肠麻痹、麻痹性肠梗阻、电解质紊乱及失代偿性碱中毒,处在生命危险当中。在经历了长达13天的饥饿、插胃管、插尿管、股静脉置管,忍受长时间静脉补液所导致的静脉炎后,患儿痊愈出院。
医生坦言:大家最好别吃隔夜西瓜, 尤其是抵抗力低的孩子和老人
隔夜西瓜细菌数以亿计
有媒体专门做过实验,分别在隔夜西瓜切面的表层、表层下4厘米处、表层下8厘米处取样,捣碎后放入培养皿。
经过48小时的培育之后,这三个样本都培养出了细菌,特别是从西瓜表层抽取部分的细菌,基本上已经覆盖了培养皿的底部,其中的细菌数量已经难以数清,需要以亿为单位计算。
关于西瓜, 你需要学会这6点!
冷藏不要超过24小时
盖上薄保鲜膜或直接放入冰箱冷藏西瓜不要超过24小时。
慎重选择保鲜膜
很多人习惯将吃剩的西瓜包上保鲜膜放冰箱!所以,保鲜膜的选择上也要慎重。如今市售的保鲜膜主要成分是聚乙烯(PE)、聚偏二氯乙烯(PVDC)和聚氯乙烯(PVC)。
前两种的安全性都是有保障的,而聚氯乙烯的保鲜膜安全性较差,不建议购买。
保证刀具和砧板的卫生
切西瓜最好使用专门的切水果刀具,尽量不要和切肉切菜的刀具混用。保证刀具和砧板的卫生,切西瓜前先用热水清洗。
切除表面1厘米再吃
保鲜膜并不是万能的,有时也会有空气漏进去,并带入细菌。所以,即使放入冰箱储存,把西瓜拿出来吃时,也要先将表面约1厘米的部分切除。
吃冰西瓜一次不超过500克
虽然大热天吃冰西瓜的解暑效果很好,但对胃的刺激很大,容易引起脾胃损伤,所以应注意把握好吃的温度和数量。每次吃的量不要超过500克,且要慢慢地吃。
西瓜这么吃才安全养生,您Get到了吗?
部分素材来源于网络,如涉侵权联系删除